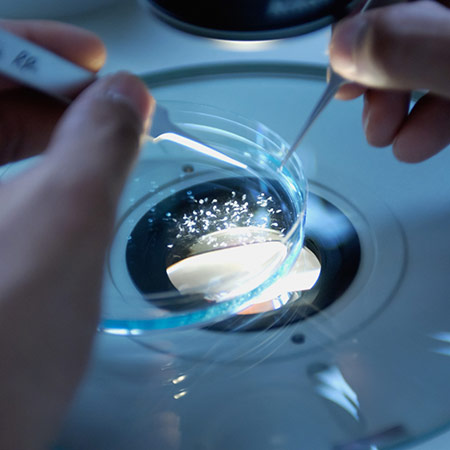

TECHNICAL INNOVATION
“Market-oriented, Accelerating Technological Innovation, and Improving Core Technological Competitiveness”, take it as the guiding ideology, LiYing Technology Center engaged in research on mechanics, biology, and thermal engineering, with the ability of researching and developing medical waste treatment technology. Industry-leading technical team with the application of professional software and hardware to allow the design and manufacture of non-standard equipment in high standards. Experimental devices such as microwave sterilization and ozone sterilization at the Test Center realize related sampling, testing, etc.



TECHNICAL ADVANTAGES
MICROWAVE AND STEAM SYNEGISTIC STERILIZATION
MICROWAVE AND STEAM SYNEGISTIC STERILIZATION, using the unique advantages of microwave and steam synergistic sterilization, the researchers developed the MDU series medical waste microwave treatment equipment series, with COMPLETE intellectual property rights and core technology.
STERILIZATION EFFECT
The disinfection requirements of HJ 229-2021 (China) that Bacillus subtilis var. Niger spores ATCC 9372 or Bacillus stearothermophilus spores ATCC 7953 or SSI K31 as indicator species to measure the bactericidal effect of microwave disinfection equipment for medical waste equipment, The microbial kill logarithmic value is greater than 4 (6 log10).
TREATMENT CAPACITY
Different equipment series and models can meet the needs of your different projects, and the processing capacity can be 100kg/ hr to 800 kg/ hr.
ENVIRONMENTAL FRIENDLY
No acid gas and dioxins and other pollutants are produced.
HIGH DEGREE OF AUTOMATION
It can be operated by ONE single person.
FLEXIBLE OPERATION
Plug and play, flexible, convenient and energy-saving.
FIXED AND MOBILE TYPE AVAILABLE
Fixed and mobile equipment can be selected, which can perfectly serve large, medium and small hospitals, medical waste centralized treatment centers, emergency treatment for epidemic or other disasters, or medical waste treatment in some remote areas.
MARKET ACCEPTANCE
With significant advantages of high sterilization rate, stable and reliable quality, small emissions, it was quickly recognized by the market after being introduced to the market.

Research and Development Achievement of Medical Waste Carbonization Equipment
Carbonization and gasification is a relatively popular method of waste treatment in the world in recent years. It is considered to be a new treatment technology that can replace incineration as it has ideal pollution control and energy efficiency.
Through several traditional and mature technologies, a new technological process has been created. Some developed countries regard it as the third-generation waste treatment technology for development.
Our researchers devoted to research of medical waste carbonization technology and have achieved staged technical achievement.
We developed the medical waste carbonization processing, with also the supporting treatment processing of waste water and exhaust gas, mastered the technology of secondary pollution control.
Carbonization equipment for medical waste treatment is designed, and a model machine has been produced.
Research and Development of Medical Waste Disposal Product Chain
The company is committed to providing a complete set of related equipment for whole project of medical waste disposal. We have developed multiple types of equipment around medical waste microwave disposal technology.
We provide or assist design solutions for professional medical waste treatment workshops, as well as automatic cleaning of turnover boxes, collection and processing solutions for waste water exhaust gas of related workshops, with corresponding processing equipment are supplied.
Over the years, we have invested and operated 19 medical waste centralized disposal centers, and accumulated rich experience in investment, construction and operation. We have the ability to provide customers with one-stop services including project design, equipment supply, installation and operation, and overall project operation planning.

TREATMENT PROCESSES
The system uses the combined effect of microwave and steam to disinfect medical waste, the treatment process is as following :
Step 1
The infectious material is temporarily held in a waste container(s) which in turn, are emptied into an pre storage hopper via a charging system which is located at the front of the MDU.
Step 2
The infectious waste is fed to the shredding system by a feed arm where it is shredded.
Step 3
The shredded material is conveyed through a microwave section and temperature holding section, respectively for disinfection under a microwave of 2450(±50) MHz, temperature of ≥95℃, over 45 minutes.
Step 4
The disinfected and unrecognizable (sharps) waste is then discharged into large waste containers (or compaction units) by the discharging screw conveyor.
Step 5
From there the material can be transported to a local municipal landfill for disposal or to a refuse recycling plant.
R&D CENTER
The company always believes that talent is the key to the company’s development. Talent first is the unchanging commitment of Liying Company, which is especially reflected in the construction and investment of environmental protection R&D teams. At present, the company has 20 technical R&D personnel and 4 senior titles (of which 2 master and doctoral students), 7 intermediate titles, and 2 overseas experts.
The R&D team of Henan Liying Environmental Science and Technology Co., Ltd. is based on R&D and design, with independent intellectual property rights as the core, and continuously improves its technical strength. The Ministry participates in R&D and implements a two-level R&D system for technology promotion, and provides solutions for the medical waste disposal industry based on microwave disposal technology.

PARTNER INSTITUTIONS
Industry-university-research cooperation has been an important way for the company’s technological progress and technological innovation. In recent years, the company’s cooperation with China University of Mining and Technology and other universities has achieved gratifying results. Especially in the development of non-standard equipment, such as the development of microwave medical waste disposal equipment, etc.; the sterilization index and environmental protection index are excellent, and the worker’s operating environment is significantly better than other equipment, which is characterized by low noise, low odor and easy operation. Greatly improved the working environment in this industry. Compared with other non-incineration processes, the emission of waste gas and wastewater from the research and development equipment is extremely low, and the odor is low, the noise is low, and the operation is simple. It has a relatively good operating environment. More importantly, through this form of cooperation, the technical team has been trained and a group of technical talents can stand out.

